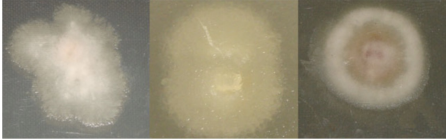
image.png

時(shí)間:2018-11-14
作者:易科泰
點(diǎn)擊量:
簡(jiǎn)介:
sisuCHEMA高光譜成像分析系統(tǒng)是一套完整的高光譜成像分析工作站,整合了VNIR至SWIR高光譜成像技術(shù)、自動(dòng)掃描技術(shù)及高光譜物質(zhì)分析技術(shù)(軟件),使用者只需要將放置在樣品盤(pán)中的待檢樣品置于推掃臺(tái)上,即可通過(guò)軟件進(jìn)行掃描控制,實(shí)時(shí)進(jìn)行光譜二維影像信息的獲取和保存,可同時(shí)對(duì)大量的樣品或不同形狀的樣品進(jìn)行光譜成像測(cè)量分析,包括組成成分/化學(xué)組成量化數(shù)據(jù)及其分布信息等,樣品最大為200x300x45mm,對(duì)10mm以下樣品其分辨率可達(dá)30 μm。

·植物表型組學(xué)研究分析
·蛋白組學(xué)研究分析
·代謝組學(xué)研究分析
·藻類(lèi)表型研究分析
·種子品質(zhì)檢測(cè)、活力檢測(cè)
·植物病理、病原檢測(cè)
·中草藥檢測(cè)研究
·根系分析
·食品檢測(cè)分析
·海洋科學(xué)研究
·環(huán)境科學(xué)
·地質(zhì)與地球科學(xué)
主要技術(shù)指標(biāo):
VNIR |
NIR |
SWIR |
|
波段范圍 |
400-1000nm |
900-1700nm |
1000-2500nm |
光譜分辨率 FWHM |
2.8nm |
6nm |
10nm |
空間分辨率/行 |
1312像素 |
320像素 |
384像素 |
像素大小 |
38 - 152 μm |
30 - 600 μm |
24 - 600 μm |
視野 |
50-200mm |
10-200mm |
10-200mm |
掃描速度 |
最大100行/秒,對(duì)應(yīng)3mm/s@30 μm像素、30mm/s@300 μm像素 |
||
掃描時(shí)間 |
320x320分辨率@256波段情況下小于7秒 |
||
照明 |
Specim 線(xiàn)性散射光源 |
||
數(shù)據(jù)格式 |
BIL格式,與ENVI兼容 |
||
校準(zhǔn) |
光譜出廠(chǎng)前已校準(zhǔn),每次掃描分析前自動(dòng)參照標(biāo)定 |
||
生命科學(xué)應(yīng)用案例:

Priscila S.R.Aries、Everaldo P. Medeiros等利用近紅外sisuCHEMA高光譜成像分析系統(tǒng)(波段范圍1000-2500nm),對(duì)棉花炭疽病等病原進(jìn)行了研究,論文發(fā)表在2018年J.Spectral Imaging(Near infrared hyperspectral images and pattern recognition techniques usedto identify etiological agents of cotton anthracnose and ramulosis)
Maxleene Sandasi、Alvaro Viljoen等,利用sisuCHEMA高光譜成像分析技術(shù),對(duì)不同品種人參進(jìn)行了定性分析研究,認(rèn)為是一種簡(jiǎn)單快速非損傷性鑒定檢測(cè)技術(shù)。論文發(fā)表在2016年Molecules(The Application of Vibrational Spectroscopy Techniques in the Qualitative Assessment of Material Traded as Ginseng)

Paul J.Williams等利用sisuCHEMA高光譜成像技術(shù),對(duì)鐮刀霉屬生長(zhǎng)特性及其品種差異進(jìn)行了研究,論文發(fā)表在2012年Anal Bioanal Chem.上(Near-infrared (NIR) hyperspectral imaging and multivariate image analysis to study growth characteristics and differences between species and strains of members of the genus Fusarium)。

地質(zhì)地球科學(xué)應(yīng)用案例:
sisuCHEMA高光譜成像分析技術(shù)廣泛應(yīng)用于金屬礦產(chǎn)和油氣資源勘探研究、環(huán)境污染監(jiān)測(cè)分析等。


聚丙烯(PP)、聚乙烯(PE)及聚苯乙烯(PS)光譜特征曲線(xiàn)及海洋污染高光譜成像分類(lèi)監(jiān)測(cè)(黃色為PS、綠色為PP、藍(lán)色為PE),研究論文:Silvia Serranti etc. Characterization of microplastic litter from oceans by an innovative approach based on hyperspectral imaging. Waste Management, 2018


左圖: 不同礦物高光譜特征吸收譜帶;
右圖引自研究論文:Richard J.Murphy etc. Consistency of Measurements of Wavelength Position From Hyperspectral Imagery: Use of the Ferric Iron Crystal Field Absorption at ~900 nm as an Indicator of Mineralogy. Transactions onGeoscience and Remote Sensing, 2014